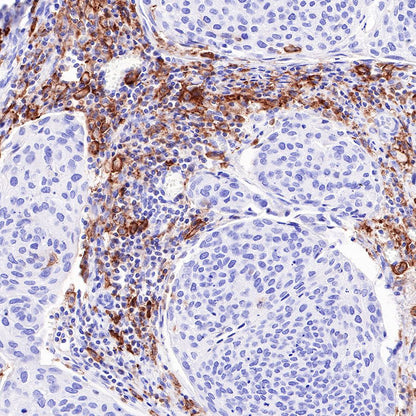
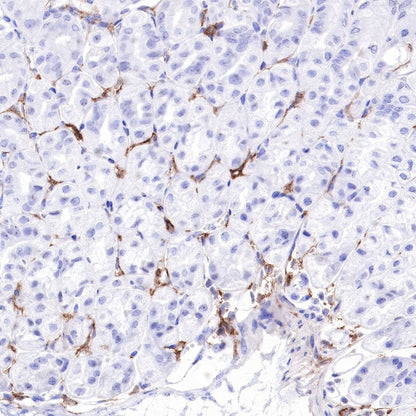

Flow cytometric analysis of 4% PFA fixed 90% methanol permeabilized Jurkat (Human T cell leukemia T lymphocyte) labelling CD16a antibody at 1/50 dilution (1 μg) / (Red) compared with a Rabbit monoclonal IgG (Black) isotype control and an unlabelled control (cells without incubation with primary antibody and secondary antibody) (Blue). Goat Anti - Rabbit IgG Alexa Fluor® 488 was used as the secondary antibody.
Product Details
Product Details
Product Specification
| Host | Rabbit |
| Antigen | CD16a |
| Synonyms | Low affinity immunoglobulin gamma Fc region receptor III-A, IgG Fc receptor III-A, CD16-II, Fc-gamma RIII-alpha, FcR-10, IgG Fc receptor III-2, FCGR3A |
| Immunogen | Synthetic Peptide |
| Location | Secreted, Cell membrane |
| Accession | P08637 |
| Clone Number | SDT-366-45 |
| Antibody Type | Recombinant mAb |
| Application | IHC-P, ICFCM, IF |
| Reactivity | Hu, Ms, Rt |
| Purification | Protein A |
| Concentration | 0.5 mg/ml |
| Physical Appearance | Liquid |
| Storage Buffer | PBS, 40% Glycerol, 0.05% BSA, 0.03% Proclin 300 |
| Stability & Storage | 12 months from date of receipt / reconstitution, -20 °C as supplied |
Dilution
| application | dilution | species |
| IHC-P | 1:500 | |
| ICFCM | 1:50 | |
| IF | 1:200 |
Background
CD16a is a transmembrane protein that acts as a receptor for the Fc portion of IgG antibodies. It is expressed on natural killer cells, monocytes, macrophages, dendritic cells, and some T cells. CD16a is also known as FCGR3A or FcγRIIIa. CD16a is involved in antibody dependent cellular cytotoxicity (ADCC) by binding to antibodies that target infected or malignant cells.
Picture
Picture
FC

Immunohistochemistry











Immunofluorescence

IF shows positive staining in paraffin-embedded human colon cancer. Anti-CD16a antibody was used at 1/200 dilution (Green) and incubated overnight at 4°C. Goat polyclonal Antibody to Rabbit IgG - H&L (Alexa Fluor® 488) was used as secondary antibody at 1/1000 dilution. Counterstained with DAPI (Blue). Heat mediated antigen retrieval with EDTA buffer pH9.0 was performed before commencing with IF staining protocol.

IF shows positive staining in paraffin-embedded human cervical squamous cell carcinoma. Anti-CD16a antibody was used at 1/200 dilution (Green) and incubated overnight at 4°C. Goat polyclonal Antibody to Rabbit IgG - H&L (Alexa Fluor® 488) was used as secondary antibody at 1/1000 dilution. Counterstained with DAPI (Blue). Heat mediated antigen retrieval with EDTA buffer pH9.0 was performed before commencing with IF staining protocol.

IF shows positive staining in paraffin-embedded human lung squamous cell carcinoma. Anti-CD16a antibody was used at 1/200 dilution (Green) and incubated overnight at 4°C. Goat polyclonal Antibody to Rabbit IgG - H&L (Alexa Fluor® 488) was used as secondary antibody at 1/1000 dilution. Counterstained with DAPI (Blue). Heat mediated antigen retrieval with EDTA buffer pH9.0 was performed before commencing with IF staining protocol.